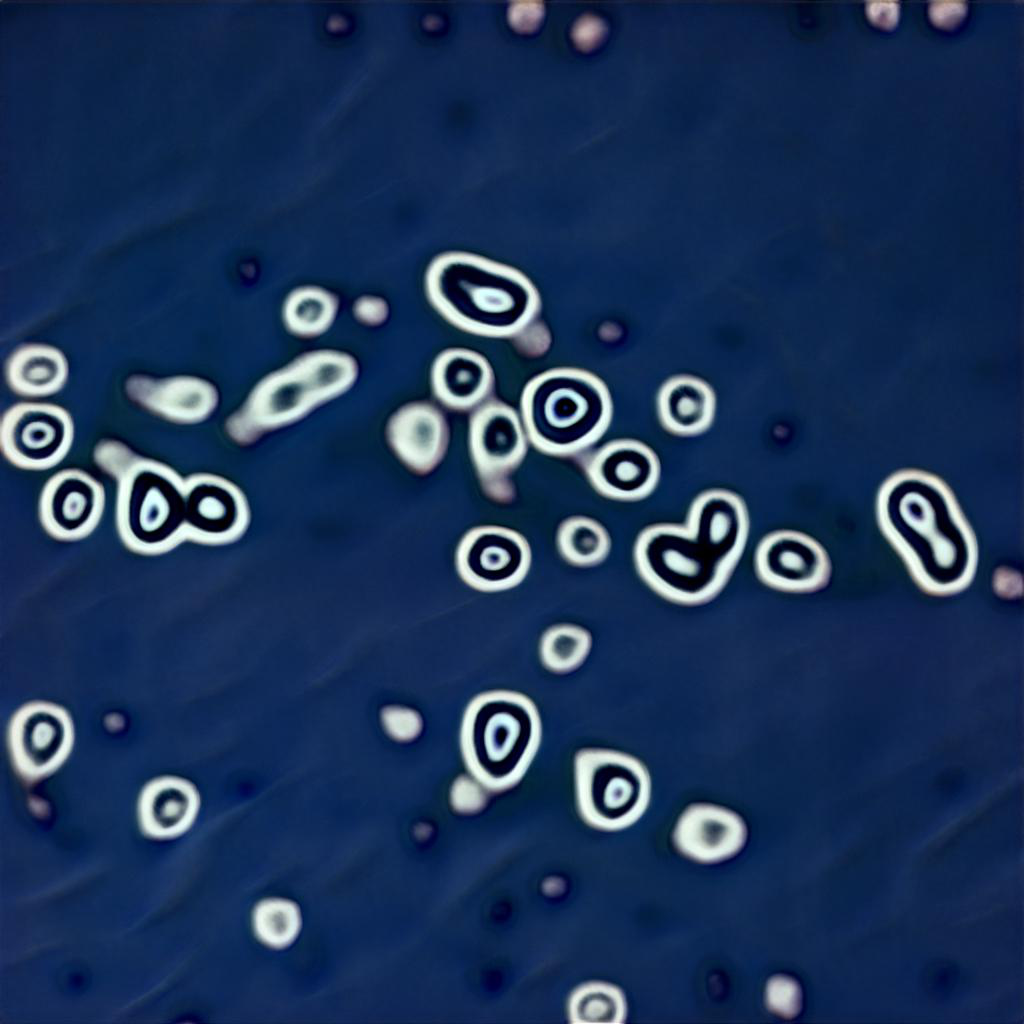

Mantenernos como especie tecno-corporal, ha requerido de la constante extracción de materias primas, a través de procesos invasivos sobre el planeta y sobre las formas de vida que lo habitan. Así, la minería del cobre ha provisto una importante base material del desarrollo tecnológico, a través de un violento proceso, cuyas alteraciones del código requieren de múltiples formas de remediación.
CUERPO / TERRITORIO
1 — Mosaico de imágenes de referencia de placas de circuitos impresos de cobre para la generación de set de datos. 2 — Mosaico de imágenes de referencia de minas de cobre para la generación de set de datos. 3 — Mosaico de imágenes de referencia de productos textiles de cobre para la generación de set de datos.
Para hacer visible el código de esta naturaleza alterada, el proyecto ha situado su mirada sobre los territorios, productos y estructuras materiales que vinculan al cobre con este desarrollo tecnológico, generando desde la captura humana de estas miradas y sus imágenes, una base sobre la cual se ha utilizado a la visión y el aprendizaje maquínico para reconocer sus patrones, códigos y alteraciones.
Así, a través de la búsqueda de imágenes disponibles en internet, se generó un dataset de 3.100 imágenes, en tres categorías. fotografías aéreas y satelitales de minas de cobre en Chile, imágenes de mallas y otros productos en base a cables de cobre, e imágenes de placas de circuitos impresos (PCB) de cobre.
Estas imágenes fueron organizadas y utilizadas en el entrenamiento de un modelo de aprendizaje maquínico, a través de la aplicación Runway ML. A través de este entrenamiento, este modelo de inteligencia artificial (entrenado originalmente para la identificación y generación de imágenes sintéticas de rostros humanos), adquirió la capacidad de identificar los patrones que componen la estructura visual de cada imagen y la estructura visual del total de las imágenes, extrayendo reglas para la generación de un número ilimitado de nuevas imágenes sintéticas.
Selección de imágenes sintéticas generadas por el modelo de aprendizaje maquínico.
Esta solicitud compositiva hecha a los algoritmos de aprendizaje maquínico, los que cruzan las imágenes de minas, circuitos, mallas de cobre – y los rostros humanos utilizados en el entrenamiento original del modelo – implica que la agencialidad de las imágenes producidas no es del todo humana. En diálogo con el referente metodológico del proyecto, aquí las imágenes que alimentan a los algoritmos corresponden a una selección humana, pero las imágenes resultantes son producidas por la máquina, la cual puede ser entendida esta como una alteración perceptiva propia de nuestra condición tecno-corporal.
El volumen de imágenes sintéticas entregadas por el modelo fue posteriormente clasificado, y se seccionaron 3 “familias” con el fin de dar cuenta tanto de la variedad como de la secuencialidad de las imágenes maquínicas. Estas imágenes mantienen las mismas propiedades del código de las imágenes originales, en términos de color y de escala, dimensiones que fueron posteriormente editadas con el fin de logra imágenes acordes a las técnicas de impresión serigráfica y a los requerimientos de continuidad propios del trabajo con tintas conductivas. Por esta razón, las imágenes fueron llevada a blanco/negro, luego a lato contraste y posteriormente sectorizadas a modo de recuperar las texturas olvidadas dentro de este proceso.
Finalmente, con las imágenes obtenidas del proceso anterior se obtuvieron matrices impresas, que permiten pasar la imagen al bastidor de serigrafía mediante un proceso de fotosensibilización de la superficie.
Secuencia de pasos con agencia humana en la edición de una imagen sintética. Ajustes y transformaciones de color, contraste, vectorización, continuidad y texturización.
Construcción set de datos: David Aveiga
Entrenamiento de modelo y tratamiento gráfico de imágenes: Juan Pablo Torrealba